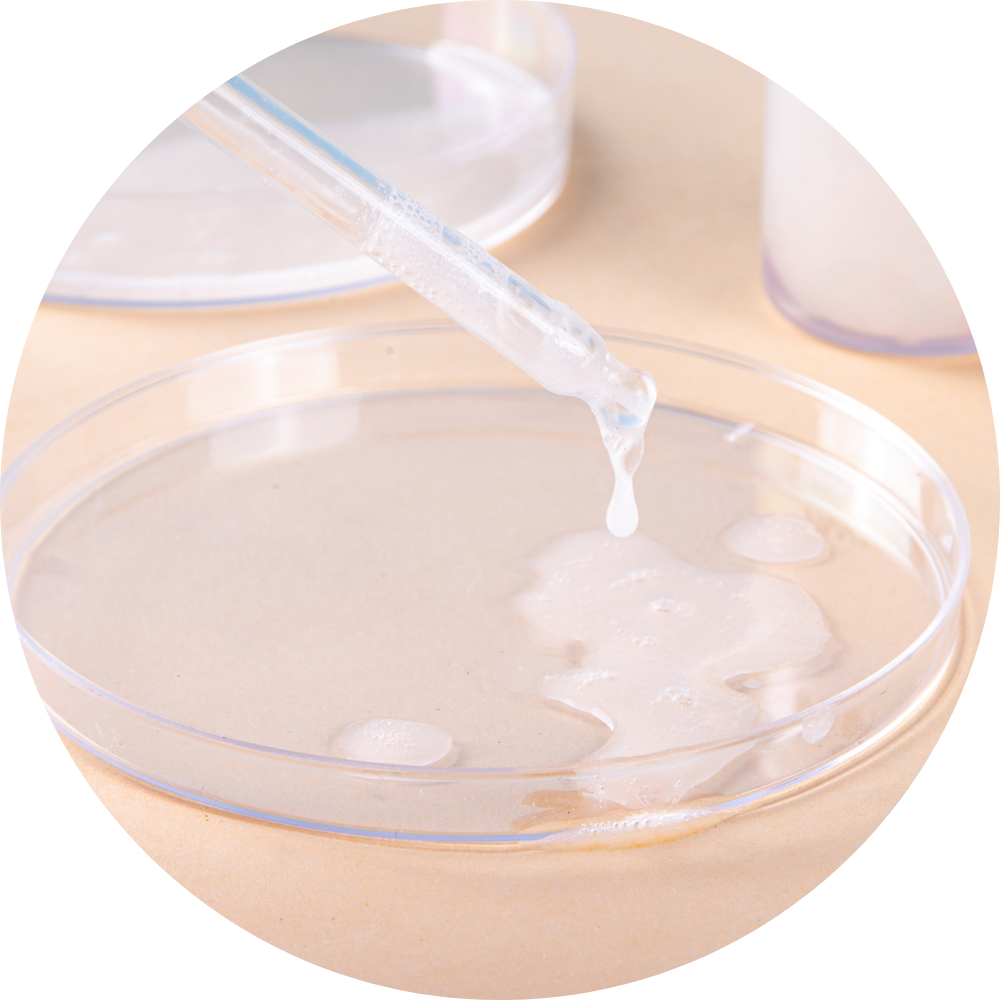

AQUA/WATER/EAU(*), OLEA EUROPAEA FRUIT OIL, CETEARYL ALCOHOL, BUTYROSPERMUM PARKII BUTTER, MYRISTYL MYRISTATE, GLYCERIN, DICAPRYLYL CARBONATE, NIACINAMIDE, SIMMONDSIA CHINENSIS
SEED OIL, STEARYL ALCOHOL, CETEARYL GLUCOSIDE, CETYL ALCOHOL, PARFUM, BUTYLENE GLYCOL, POTASSIUM CETYL PHOSPHATE, TOCOPHERYL ACETATE, TREHALOSE, LONICERA CAPRIFOLIUM FLOWER EXTRACT, JOJOBA ESTERS, LACTIC ACID, CETYL PALMITATE, HELIANTHUS ANNUUS SEED WAX, LECITHIN, SORBITAN OLIVATE, SORBITAN PALMITATE, LONICERA JAPONICA FLOWER EXTRACT, PANTHENOL, SODIUM LAUROYL LACTYLATE, ALPHA-ARBUTIN, ESCIN, TOCOPHEROL, RUSCUS ACULEATUS ROOT EXTRACT, ASCORBYL PALMITATE, ACACIA DECURRENS FLOWER WAX, POLYGLYCERIN-3, AMMONIUM GLYCYRRHIZATE, CERAMIDE NP, CENTELLA ASIATICA LEAF EXTRACT, MALTODEXTRIN, CAMELLIA SINENSIS LEAF(BLUE TEA)(*), PHYTOSPHINGOSINE, CERAMIDE AP, CHOLESTEROL, HYDROLYZED YEAST PROTEIN, CALENDULA OFFICINALIS FLOWER EXTRACT, CENTELLA ASIATICA EXTRACT, CARBOMER, XANTHAN GUM, CITRIC ACID, CERAMIDE EOP. (*)TEA INFUSION
Tube : Laminate material to be disposed of in the undifferentiated
Cap : 100% recyclable plastic
Complete your skincare ritual

Skin Types


Skin Concerns




Key ingredients

Organic Blue Tea
Brightens and hydrates the skin while providing energizing and stimulating effects.
Natural Ceramides
Protects the skin from external aggressions and dehydrations, smooth, illuminate and soften signs of stress and fatigue.

Niacinamide
Improves skin appearance by reducing inflammation, regenerates the damaged skin barrier.

Olive Oil
Nourishes the skin and regulates hydration.
Frequently Asked Questions
Everything you need to know about this beauty product.
To use the 4-in-1 Beauty Balm, apply a small amount as a moisturizer to hydrate your skin. You can also use it as a primer before makeup for a smooth base. For an added boost, dab it on as an eye cream to hydrate the delicate eye area, or apply a thicker layer as a night mask to nourish your skin overnight.